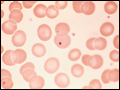
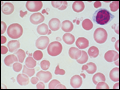

PART 2: Cardinal Manifestations and Presentation of Diseases
SECTION 10 Hematologic Alterations
57 Anemia and Polycythemia
 | Figure 57-1 The physiologic regulation of red cell production by tissue oxygen tension. Hb, hemoglobin. |
view large |
 | Figure 57-2 Erythropoietin (EPO) levels in response to anemia. When the hemoglobin level falls to 120 g/L (12 g/dL), plasma EPO levels increase logarithmically. In the presence of chronic kidney disease or chronic inflammation, EPO levels are typically lower than expected for the degree of anemia. As individuals age, the level of... |
view large |
 | Figure 57-3 Normal blood smear (Wright stain). High-power field showing normal red cells, a neutrophil, and a few platelets. (From Hillman et al.) |
view large |
 | Figure 57-4 Severe iron-deficiency anemia. Microcytic and hypochromic red cells smaller than the nucleus of a lymphocyte associated with marked variation in size (anisocytosis) and shape (poikilocytosis). (From Hillman et al.) |
view large |
 | Figure 57-5 Macrocytosis. Red cells are larger than a small lymphocyte and well hemoglobinized. Often macrocytes are oval shaped (macro-ovalocytes). |
view large |
| Figure 57-6 Howell-Jolly bodies. In the absence of a functional spleen, nuclear remnants are not culled from the red cells and remain as small homogeneously staining blue inclusions on Wright stain. (From Hillman et al.) |
view large |
 | Figure 57-7 Red cell changes in myelofibrosis. The left panel shows a teardrop-shaped cell. The right panel shows a nucleated red cell. These forms are seen in myelofibrosis. |
view large |
 | Figure 57-8 Target cells. Target cells have a bull's-eye appearance and are seen in thalassemia and in liver disease. (From Hillman et al.) |
view large |
| Figure 57-9 Red cell fragmentation. Red cells may become fragmented in the presence of foreign bodies in the circulation, such as mechanical heart valves, or in the setting of thermal injury. (From Hillman et al.) |
view large |
 | Figure 57-10 Uremia. The red cells in uremia may acquire numerous regularly spaced, small, spiny projections. Such cells, called burr cells or echinocytes, are readily distinguishable from irregularly spiculated acanthocytes shown in Fig. 57-11. |
view large |
 | Figure 57-11 Spur cells. Spur cells are recognized as distorted red cells containing several irregularly distributed thornlike projections. Cells with this morphologic abnormality are also called acanthocytes. (From Hillman et al.) |
view large |
 | Figure 57-12 Reticulocytes. Methylene blue stain demonstrates residual RNA in newly made red cells. (From Hillman et al.) |
view large |
 | Figure 57-13 Correction of the reticulocyte count. In order to use the reticulocyte count as an indicator of effective red cell production, the reticulocyte percentage must be corrected based on the level of anemia and the circulating life span of the reticulocytes. Erythroid cells take ~4.5 days to mature. At a normal hemoglobin,... |
view large |
 | Figure 57-14 Normal bone marrow. This is a low-power view of a section of a normal bone marrow biopsy stained with hematoxylin and eosin (H&E). Note that the nucleated cellular elements account for ~40–50% and the fat (clear areas) accounts for ~50–60% of the area. (From Hillman et... |
view large |
 | Figure 57-15 Erythroid hyperplasia. This marrow shows an increase in the fraction of cells in the erythroid lineage as might be seen when a normal marrow compensates for acute blood loss or hemolysis. The M/E ratio is about 1:1. M/E, myeloid/erythroid. (From Hillman et al.) |
view large |
 | Figure 57-16 Myeloid hyperplasia. This marrow shows an increase in the fraction of cells in the myeloid or granulocytic lineage as might be seen in a normal marrow responding to infection. The M/E ratio is >3:1. M/E, myeloid/erythroid. (From Hillman et al.) |
view large |
 | Figure 57-17 The physiologic classification of anemia. CBC, complete blood count. |
view large |
 | Figure 57-18 An approach to the differential diagnosis of patients with an elevated hemoglobin (possible polycythemia). AV, atrioventricular; COPD, chronic obstructive pulmonary disease; EPO, erythropoietin; hct, hematocrit; IVP, intravenous pyelogram; RBC, red blood cell. |
view large |

